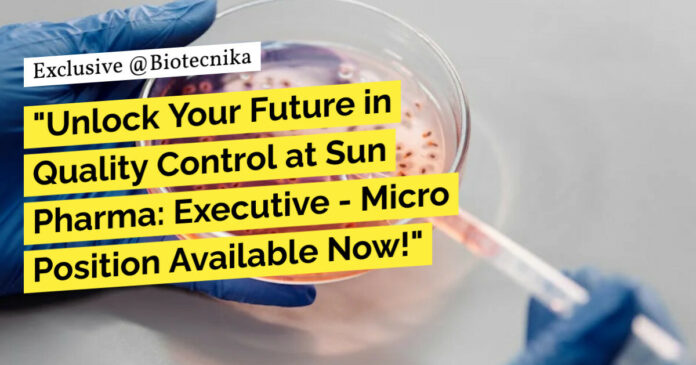

--Must See--
Quality Control at Sun Pharma: Executive – Micro Position Available Now!
Title: Executive – Micro
Date: Jul 18, 2024
Location: Mohali – Quality Control
Company: Sun Pharmaceutical Industries Ltd
Responsibility:
- Ensure compliance to cGMP and safety standards in the QC laboratory
- Conduct calibration and cleaning of laboratory equipment and instruments as per SOP
- Culture Media preparation and sterilization
- To perform growth promotion test of culture media
- Maintenance of microbial culture
- Document analytical data and calculate results
- Maintain laboratory equipment, inventory and supplies
- Ensure integrity, accuracy and adequacy of the analysis performed
- Follow GLP activities and ensure their compliance
- Conduct microbiological sampling and testing of samples
- Conduct environmental monitoring
- Identification of microorganism through Vitek 2 system
- Daily Laboratory Monitoring including Temperature/Humidity and Testo Printout
- Management of issuance and archival of log books and formats
- Maintenance of various documents and records in Microbiology Lab
- To assist in validation/Qualification exercise and any other assignment given by Lab In-charge / Mgr. Quality Control from time to time
Apply for this position at: Apply Here
Keywords: Executive Micro, Sun Pharmaceutical, Quality Control, Compliance, Microbiology Lab, Laboratory Equipment. Quality Control at Sun Pharma: Executive – Micro Position Available Now! Please ensure you are subscribed to the Biotecnika Times Newsletter and our YouTube channel to be notified of the latest industry news. Follow us on social media like Twitter, Telegram, Facebook